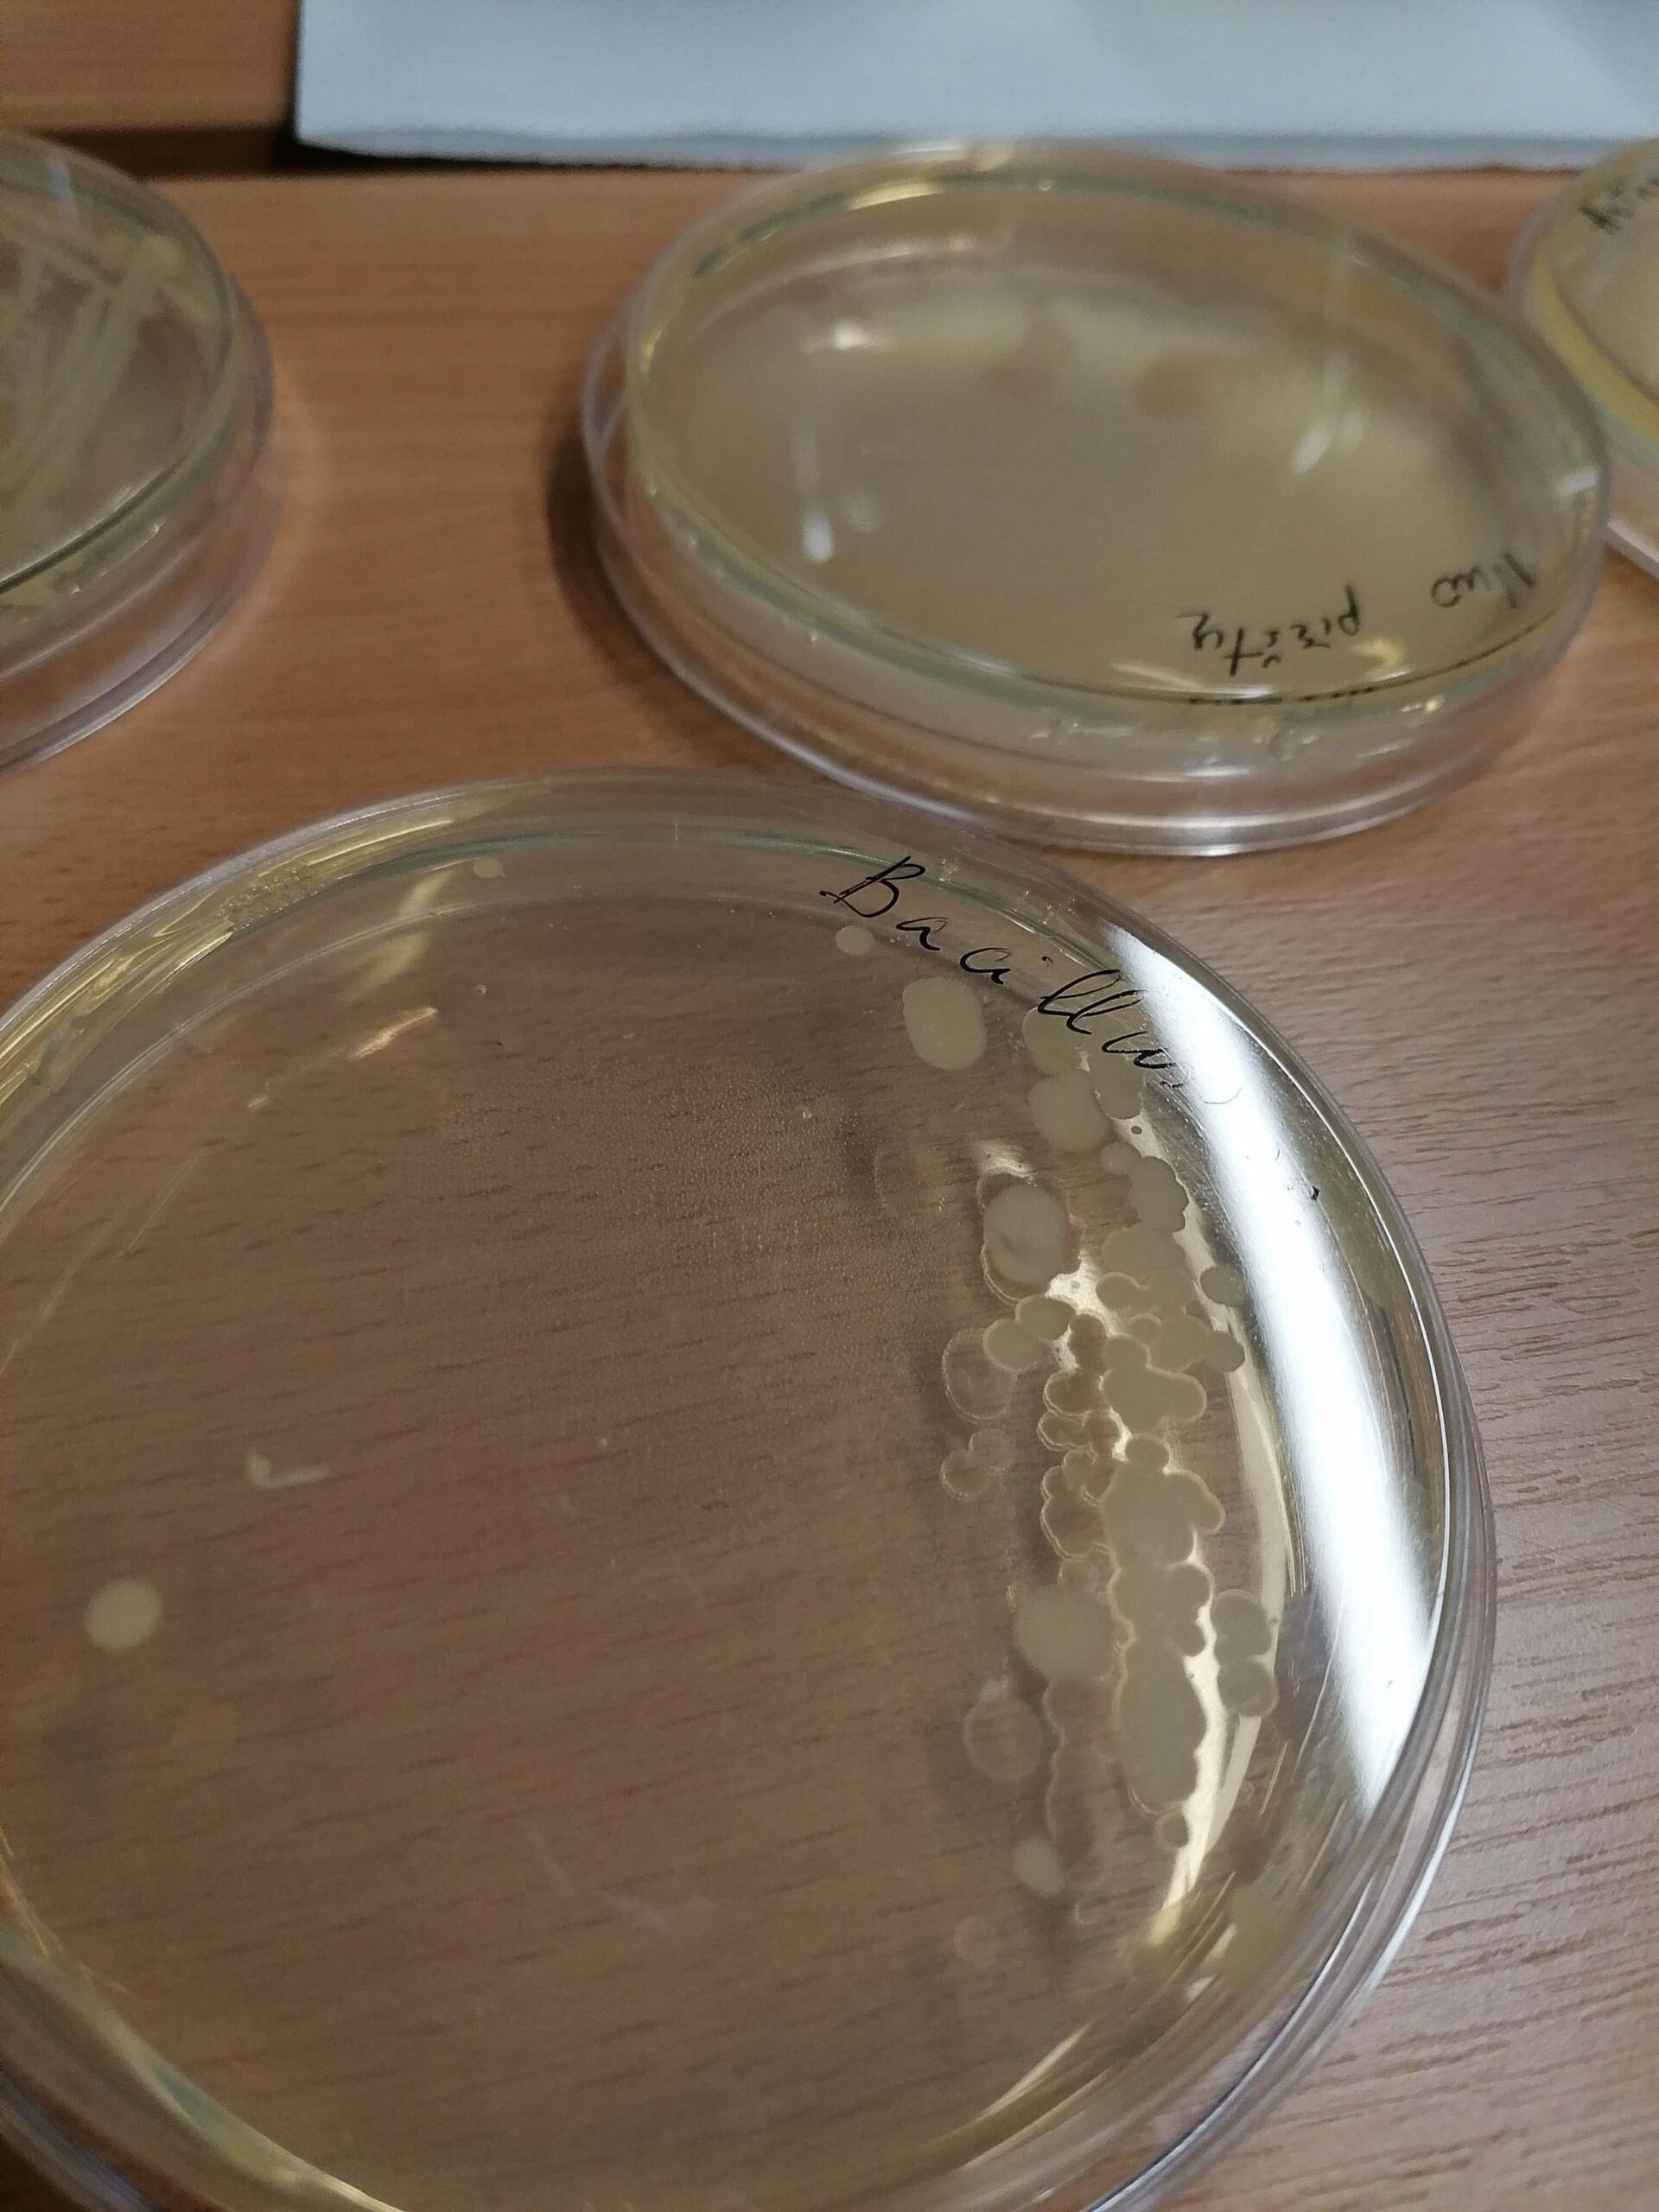

Lapkričio 16 d. per 60 I–III kl. gimnazistų dalyvavo Jaunojo tyrėjo projekto „Mokinių gebėjimų atskleidimo ir jų ugdymo sistemos plėtra“ veiklose. Projektą organizavo Nacionalinė švietimo agentūra, Lietuvos mokinių neformaliojo švietimo centras. Mobiliojoje laboratorijoje dvi mokinių grupės atliko mikrobiologinius tyrimus ir, panaudodami elektroforezę, genetinį tyrimą.
IIG kl. mokiniai, susiskirstę į dvi grupes, tyrė iš vandens telkinio parsinešto vandens savybes, cheminę jo sudėtį bei stebėjo vandenyje gyvenančius bestuburius.
„Pasisėmę vandens iš Talkšos ežero ir Vijolės upelio, grįžome į gimnaziją ir atlikome bandymus (nustatėme vandens pH, kietumą, išsiaiškinome, kiek vandenyje yra azoto dioksido, nitratų, fosfatų bei amonio rūgšties). Baigę tyrimus, padarėme išvadą, jog Talkšos ežero vanduo yra pakankamai geras, pagal žuvininkystės reikalavimus ten gali veistis žuvys, o Vijolės upelio vanduo – prastesnis. Be to, susipažinome su paviršinių vandens telkinių monitoringu, jo metodika. Ši patirtis mums buvo labai įdomi ir naudinga. Turėjome progą išbandyti darbą su dar nebandytomis priemonėmis, artimiau susipažinome su atliekamais vandens tyrimais, apie kuriuos daugelis nebuvo net girdėję.” (Vidmantė Mauragaitė, IIG kl. mokinė)
„Mus, gimnazistus, pasitiko dvi mikrobiologės Inga ir Milda. Stebėdami pro mikroskopą, pasitikrinome turimas žinias apie žmogaus audinius, įvairiomis cheminėmis medžiagomis dažėme bakterijas, kad pro mikroskopą galėtume pamatyti. Taigi grįžome su naujomis žiniomis ir patirtimis. Džiaugiamės, kad turėjome galimybę padirbėti mobilioje laboratorijoje.“ (Simona Mickutė, IIIc kl. mokinė)
Geros savijautos programoje „Inovatyvus mąstymas ir efektyvus mokymasis“ dalyvavo IG kl. mokiniai. Džiaugiamės, kad esame viena iš 40-ies Lietuvos mokyklų, kurios mokiniai buvo pakviesti į Jaunojo tyrėjo laboratoriją! Čia mokiniai atranda, kad pasaulis yra vientisas, čia išnyksta ribos tarp atskirų mokyklinių dalykų, čia suprantama, kad pažinimas yra begalinis ir be galo įdomus.
Romualda Pupinytė, direktoriaus pavaduotoja